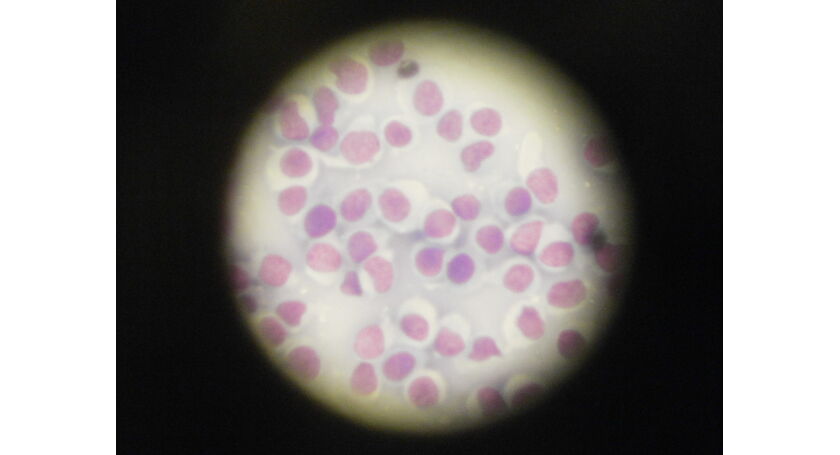

犬のデキモノ 赤い皮膚腫瘤 医療情報 院長ブログ さいたま市にある当動物病院で犬 ネコの避妊手術 去勢手術
犬 背中 できもの 赤い
犬 背中 できもの 赤い-




犬のイボ できものは良性か悪性か 症状 原因 解決法7つ Zehitomo Journal




犬のできもの ピンクでカリフラワー状のイボを取った話 画像や切除料金 方法まとめ まいにちrainbow



獣医師監修 愛犬の体にできもの発見 色や形で推測できる皮膚の病気と肌トラブルの対策方法




膿皮症 毛が抜ける 皮膚が赤い場合は要注意 症状や予防策など 柴犬ライフ Shiba Inu Life




犬が体をかく8つの理由 その症状 皮膚炎へつながることも 皮膚炎 前編 アクサダイレクト



至急犬の背中 お尻近く のできものについて 先程 犬の背中を撫でている Yahoo 知恵袋




画像 犬 背中 こぶ 家のイラスト




数ヶ月前から愛犬の背中にできていたしこり が 今確認したところ赤く 犬 教えて Goo




こんな症状 ありませんか 犬と猫の皮膚科




犬の膿皮症の基礎知識 症状 治療 自宅でのケアについて わんちゃんホンポ




犬の皮膚にかさぶたができる原因 治療法について なんよう動物病院 知立市 刈谷市の動物病院




膿皮症 毛がぬけて皮膚が赤くなっていたら要注意 フレンチブルドッグライフ




ガクの皮膚状態 今朝の嘔吐 コーギー犬 ガクと一緒




皮膚科 毛が抜ける 皮膚が赤い 体を掻く なめる 宝塚まりも動物病院 宝塚市 動物病院 歯科 腫瘍科 猫診察など



犬のできものについて犬の首筋にニキビのようなものができました 触っても痛がる様 Yahoo 知恵袋




獣医師監修 犬のがんの早期発見チェック項目と 原因 対処法を解説 犬の生活 Sbiいきいき少短



2




ノミ ダニ予防 武井動物病院 東京都国立市



皮膚のデキモノ 習志野動物医療センター りょう動物病院




Freemuryovldfsq 犬 お腹 赤い 斑点 犬 お腹 赤い 斑点




獣医師監修 犬の皮膚が赤い 皮膚がただれている この症状から考えられる原因や病気は Hotto ホット




獣医師監修 写真で判別する 皮膚疾患 代表的な5つの病気 Petowa



犬



獣医師監修 愛犬の体にできもの発見 色や形で推測できる皮膚の病気と肌トラブルの対策方法



画像 犬 背中 こぶ 家のイラスト




犬の皮膚が赤い 痒そう おでかけに潜む皮膚トラブルの原因と予防 Honda Dog Honda




犬の膿皮症の症状 原因と治療法について獣医師が解説 価格 Com



犬イボ塗り薬




愛犬の できもの が破裂し出血 考えられる病名は 犬 猫との幸せな暮らしのためのペット情報サイト Sippo

犬のデキモノ 赤い皮膚腫瘤 医療情報 院長ブログ さいたま市にある当動物病院で犬 ネコの避妊手術 去勢手術



犬の皮膚がん 写真




犬のできもの ピンクでカリフラワー状のイボを取った話 画像や切除料金 方法まとめ まいにちrainbow




老犬の皮膚のできもの 原因や見分け方やケア方法は 病気 おすすめ商品は Pepy




気になる湿疹は膿皮症 原因や治療法を獣医さんに聞きました アクサダイレクト




背中に赤いスプレーで タダ と書かれたまま道路脇に捨てられた犬



2




犬の背中にできものが 原因は膿皮症でした けだま生活



犬にもニキビができる 膿皮症の対策 治療法を画像付きで解説します まつごろう王国



犬の背中あたりにポツンとニキビのようなものを先程みつけました 触って Yahoo 知恵袋




獣医師監修 犬の皮膚病 気になる症状と原因を解説 犬の生活 Sbiいきいき少短




犬にかさぶたができる原因って何 皮膚病や腫瘍の可能性もあるの




7歳mix犬の手に硬く赤いできものを見つけました 昨日晩に気が付いた 犬 教えて Goo



飼っている犬の前足に 赤いできものができていました 気になるよう Yahoo 知恵袋




犬のイボ できものは良性か悪性か 症状 原因 解決法7つ Zehitomo Journal



皮膚病 症例紹介 診療案内 三重動物医療センター なるかわ動物病院




獣医師監修 犬の皮膚が赤い 皮膚がただれている この症状から考えられる原因や病気は Hotto ホット




獣医師監修 犬の皮膚が赤い 皮膚がただれている この症状から考えられる原因や病気は Hotto ホット




獣医師解説 犬にかさぶたができる原因や病気とは 取ろうとする場合の対処法などを解説 ペトコト




犬のしこり 腫瘍の原因 病気とは 病院に連れて行くべき症状を獣医が解説 ペット保険の Ps保険 少額短期保険ペットメディカルサポート株式会社




獣医師監修 写真で判別する 皮膚疾患 代表的な5つの病気 Petowa




獣医師解説 犬にかさぶたができる原因や病気とは 取ろうとする場合の対処法などを解説 ペトコト




犬の皮膚病対策まとめ お腹や背中に湿疹ができた場合のケア方法 Pepy




尻尾に赤いできもの 質問と回答 だいじょうぶ マイペット




かさぶたや湿疹に要注意 わんちゃんによくある皮膚病 ポックル動物病院 札幌市手稲区 犬 猫 小動物




獣医師監修 犬の皮膚病 気になる症状と原因を解説 犬の生活 Sbiいきいき少短



顎にあかいできものがあります 質問と回答 だいじょうぶ マイペット




愛犬の皮膚が赤くなっている 皮膚が赤くなってしまう原因や自宅でのケア方法を紹介



皮膚病 症例紹介 診療案内 三重動物医療センター なるかわ動物病院




犬のしこり 腫瘍の原因 病気とは 病院に連れて行くべき症状を獣医が解説 ペット保険の Ps保険 少額短期保険ペットメディカルサポート株式会社



皮膚にできたイボから出血が という例 形質細胞腫 院長ブログ うぇる動物病院 町田市本町田の動物病院 犬猫の予防接種 夜間診療 ペットホテル




犬の アレルギー性皮膚炎 原因や症状 治療についてご紹介 犬との暮らし大百科




背中のできものについて 質問と回答 だいじょうぶ マイペット




犬のかさぶたができる原因 病気とは 病院に連れて行くべき症状を獣医が解説 ペット保険の Ps保険 少額短期保険ペットメディカルサポート株式会社




犬にもニキビができる 膿皮症の対策 治療法を画像付きで解説します まつごろう王国




犬のしこり 腫瘍の原因 病気とは 病院に連れて行くべき症状を獣医が解説 ペット保険の Ps保険 少額短期保険ペットメディカルサポート株式会社




獣医師解説 犬にかさぶたができる原因や病気とは 取ろうとする場合の対処法などを解説 ペトコト




犬の皮膚が赤い 痒そう おでかけに潜む皮膚トラブルの原因と予防 Honda Dog Honda




犬の皮膚が赤い 痒そう おでかけに潜む皮膚トラブルの原因と予防 Honda Dog Honda



皮膚に発生する できもの いろいろ 院長ブログ うぇる動物病院 町田市本町田の動物病院 犬猫の予防接種 夜間診療 ペットホテル




獣医師監修 写真で判別する 皮膚疾患 代表的な5つの病気 Petowa



肉球近くのできもの 質問と回答 だいじょうぶ マイペット




犬のかゆみ かゆみの原因と対処 予防方法 ぽちたま薬局



犬の足に赤いこぶ が出来ています 助けて下さい お願いします 写真はっとき Yahoo 知恵袋



皮膚病 症例紹介 診療案内 三重動物医療センター なるかわ動物病院




犬の皮膚が赤い 痒そう おでかけに潜む皮膚トラブルの原因と予防 Honda Dog Honda




老犬の皮膚のできもの 原因や見分け方やケア方法は 病気 おすすめ商品は Pepy




獣医師監修 犬のイボやしこりの種類と悪性 良性 色 形の特徴 治療法を解説 いぬのきもちweb Magazine




犬の背中にピンク色の できもの が ピンク色の できもの の種類 病気 愛犬毎日元気だワン 犬の健康を第一に考える情報サイト




犬の背中はしこりができやすい 小さくて柔らかい膿ができる原因と見つけた場合の対処法3選 Poppet ポペット ペット大好き



犬




犬にもニキビができる 症状や予防について わんちゃんホンポ




愛犬の皮膚が赤くなっている 皮膚が赤くなってしまう原因や自宅でのケア方法を紹介



犬のできものについて トイプードル9歳を飼っています 1週間ほど前に耳の上あた Yahoo 知恵袋




犬にかさぶたができる原因って何 皮膚病や腫瘍の可能性もあるの




犬がしきりに体をかく原因とは 病院に連れて行くべき症状を獣医が解説 ペット保険の Ps保険 少額短期保険ペットメディカルサポート株式会社




広告 老犬ケア 老犬ホーム 老猫ホーム情報サイト




犬に多い皮膚病の種類 かさぶたや体が臭い原因は 薬だけで治る




犬にしこり 腫瘍を見つけたら 考えられる病気は すぐ病院へ行くべき 犬との暮らし大百科




獣医師解説 犬にかさぶたができる原因や病気とは 取ろうとする場合の対処法などを解説 ペトコト



皮膚にできたイボから出血が という例 形質細胞腫 院長ブログ うぇる動物病院 町田市本町田の動物病院 犬猫の予防接種 夜間診療 ペットホテル




犬の首に赤いできもの 犬の首の辺りに赤いできものがありました 写真を見て Okwave




獣医師監修 犬の皮膚が赤い 皮膚がただれている この症状から考えられる原因や病気は Hotto ホット




犬のしこりから考えられる病気と悪性と良性の違い わんちゃんホンポ



愛犬にイボ 犬の皮膚にイボができてしまった時の3つの対処法 Alphaicon アルファアイコン 機能性ドッグウェア 犬服 の アルファアイコン オフィシャルサイト




犬のできものと病気について わんちゃんホンポ




膿皮症 Case Report かみや動物クリニック




犬の皮膚に異変 気になるイボについて プレミアムドッグフード専門店 通販 Pochi ポチ公式サイト




老犬の皮膚のできもの 原因や見分け方やケア方法は 病気 おすすめ商品は Pepy




犬の膿皮症とは 原因と治療法について 知立市のなんよう動物病院




こんな症状 ありませんか 犬と猫の皮膚科




皮膚科 皮膚病の治療 あだち動物病院




犬の膿皮症の基礎知識 症状 治療 自宅でのケアについて わんちゃんホンポ




獣医師監修 犬のお腹が赤い この症状から考えられる原因や主な病気は Hotto ホット




犬の皮膚病でよくある4つの症状と治療方法について 知立市のなんよう動物病院



皮膚にできたイボから出血が という例 形質細胞腫 院長ブログ うぇる動物病院 町田市本町田の動物病院 犬猫の予防接種 夜間診療 ペットホテル



0 件のコメント:
コメントを投稿